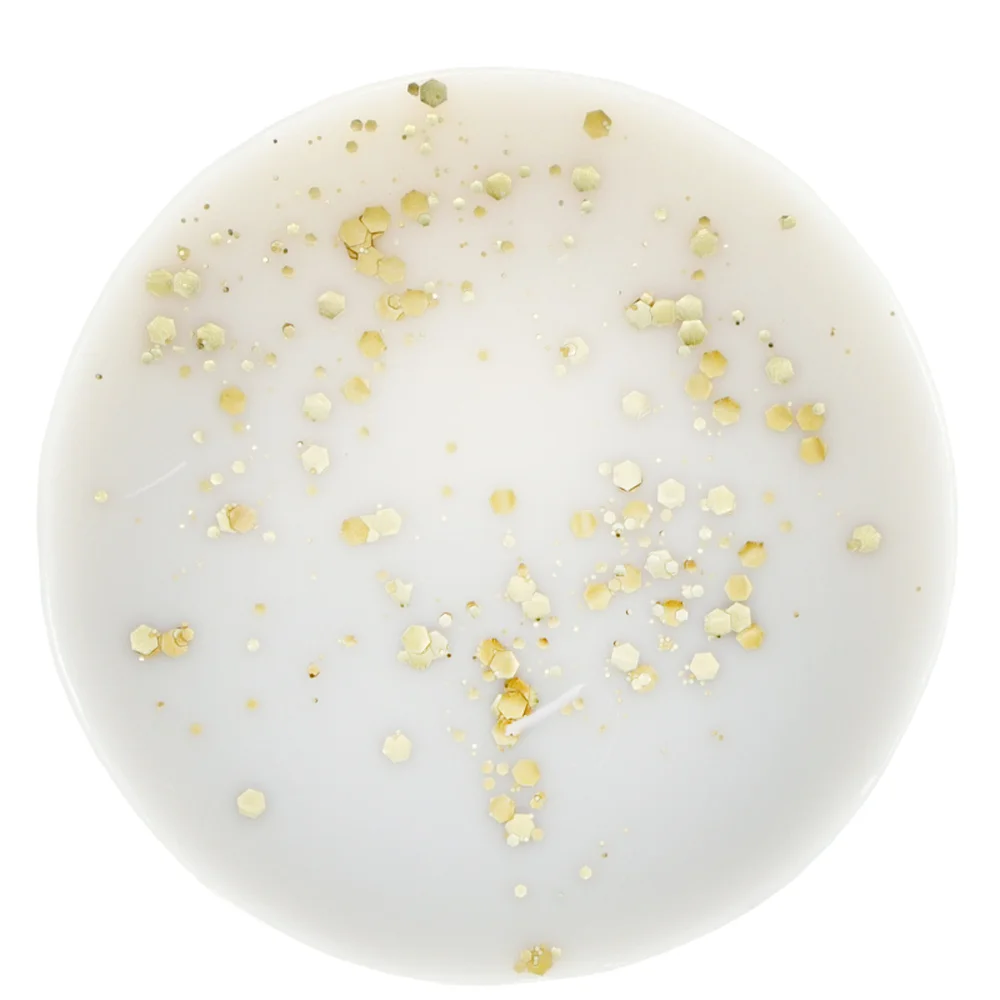
Sassy Shop Wax Wax Melt Amber - 70g Image 1

Save to wishlist
The pot hold 70g of scented wax, giving over 60+ hours worth of scent in every pot.
A powdery fresh scent with floral notes of gardenia, bergamot and ylang-ylang with a hint of mandarin on a base of sweet vanilla.
To use:
Break off a cube or two from your wax bar (depending on your burner size), add a tea light underneath and light the wick. For best results, always close your windows in the room you are burning the wax.
Please check the packaging for allergen advice. Keep away from children. Never leave an in-use burner unattended.
Vegan & Cruelty-Free
Handmade in the UK
Bio-Degradable Glitter
Wax Melt
All Customer Reviews
There are currently no reviews.
Write a review?